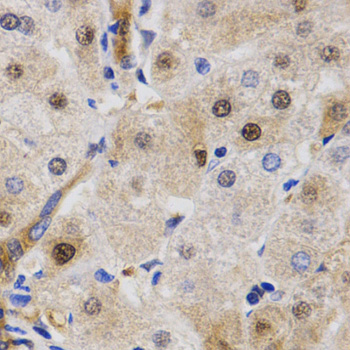
product-image-AAA301042_IHC13.jpg

UV excision repair protein RAD23 homolog A Recombinant Protein | RAD23A recombinant protein
Recombinant Human UV excision repair protein RAD23 homolog A
Gene Names
RAD23A; HR23A; HHR23A
Purity
Greater or equal to 85% purity as determined by SDS-PAGE.
Synonyms
UV excision repair protein RAD23 homolog A; N/A; Recombinant Human UV excision repair protein RAD23 homolog A; RAD23A recombinant protein
Host
E Coli or Yeast or Baculovirus or Mammalian Cell
Purity/Purification
Greater or equal to 85% purity as determined by SDS-PAGE.
Form/Format
Lyophilized or liquid (Format to be determined during the manufacturing process)
Sequence Positions
1-363aa; Full Length
Sequence
MAVTITLKTLQQQTFKIRMEPDETVKVLKEKIEAEKGRDAFPVAGQKLIYAGKILSDDVPIRDYRIDEKNFVVVMVTKTKAGQGTSAPPEASPTAAPESSTSFPPAPTSGMSHPPPAAREDKSPSEESAPTTSPESVSGSVPSSGSSGREEDAASTLVTGSEYETMLTEIMSMGYERERVVAALRASYNNPHRAVEYLLTGIPGSPEPEHGSVQESQVSEQPATEAAGENPLEFLRDQPQFQNMRQVIQQNPALLPALLQQLGQENPQLLQQISRHQEQFIQMLNEPPGELADISDVEGEVGAIGEEAPQMNYIQVTPQEKEAIERLKALGFPESLVIQAYFACEKNENLAANFLLSQNFDDE
Sequence Length
363
Production Note
Special Offer: The E Coli host-expressed protein is manufactured from a stock plasmid containing the protein gene. E Colihost-expressed protein is stocked in different unit sizes ranging from as small as 10 ug to as large as 1 mg. Bulk inventory is also available. The E Coli host-expressed protein has been ordered over and over again by researchers and has stood the test of time as both a robust protein and important target for the research community. It is part of our new program to make our most popular protein targets and corresponding hosts available in expanded unit sizes and with a quick processing time. Select E Coli host-expressed protein for the fastest delivery among all hosts. Please contact our or email to for more details.
Preparation and Storage
Store at -20 degree C, for extended storage, conserve at -20 degree C or -80 degree C.
Related Product Information for RAD23A recombinant protein
Multiubiquitin chain receptor involved in modulation of proteasomal degradation. Binds to 'Lys-48'-linked polyubiquitin chains in a length-dependent manner and with a lower affinity to 'Lys-63'-linked polyubiquitin chains. Proposed to be capable to bind simultaneously to the 26S proteasome and to polyubiquitinated substrates and to deliver ubiquitinated proteins to the proteasome. Involved in nucleotide excision repair and is thought to be functional equivalent for RAD23B in global genome nucleotide excision repair (GG-NER) by association with XPC. In vitro, the XPC:RAD23A dimer has NER activity. Can stabilize XPC. Involved in vpr-dependent replication of HIV-1 in non-proliferating cells and primary macrophages. Required for the association of HIV-1 vpr with the host proteasome.
Product Categories/Family for RAD23A recombinant protein
References
Purification and cloning of a nucleotide excision repair complex involving the Xeroderma pigmentosum group C protein and a human homologue of yeast RAD23.Masutani C., Sugasawa K., Yanagisawa J., Sonoyama T., Ui M., Enomoto T., Takio K., Tanaka K., van der Spek P.J., Bootsma D., Hoeijmakers J.H.J., Hanaoka F.EMBO J. 13:1831-1843(1994) NIEHS SNPs programFull-length cDNA libraries and normalization.Li W.B., Gruber C., Jessee J., Polayes D. Homo sapiens protein coding cDNA.Totoki Y., Toyoda A., Takeda T., Sakaki Y., Tanaka A., Yokoyama S., Ohara O., Nagase T., Kikuno R.F. The DNA sequence and biology of human chromosome 19.Grimwood J., Gordon L.A., Olsen A.S., Terry A., Schmutz J., Lamerdin J.E., Hellsten U., Goodstein D., Couronne O., Tran-Gyamfi M., Aerts A., Altherr M., Ashworth L., Bajorek E., Black S., Branscomb E., Caenepeel S., Carrano A.V., Caoile C., Chan Y.M., Christensen M., Cleland C.A., Copeland A., Dalin E., Dehal P., Denys M., Detter J.C., Escobar J., Flowers D., Fotopulos D., Garcia C., Georgescu A.M., Glavina T., Gomez M., Gonzales E., Groza M., Hammon N., Hawkins T., Haydu L., Ho I., Huang W., Israni S., Jett J., Kadner K., Kimball H., Kobayashi A., Larionov V., Leem S.-H., Lopez F., Lou Y., Lowry S., Malfatti S., Martinez D., McCready P.M., Medina C., Morgan J., Nelson K., Nolan M., Ovcharenko I., Pitluck S., Pollard M., Popkie A.P., Predki P., Quan G., Ramirez L., Rash S., Retterer J., Rodriguez A., Rogers S., Salamov A., Salazar A., She X., Smith D., Slezak T., Solovyev V., Thayer N., Tice H., Tsai M., Ustaszewska A., Vo N., Wagner M., Wheeler J., Wu K., Xie G., Yang J., Dubchak I., Furey T.S., DeJong P., Dickson M., Gordon D., Eichler E.E., Pennacchio L.A., Richardson P., Stubbs L., Rokhsar D.S., Myers R.M., Rubin E.M., Lucas S.M.Nature 428:529-535(2004) Human immunodeficiency virus type 1 Vpr interacts with HHR23A, a cellular protein implicated in nucleotide excision DNA repair.Withers-Ward E.S., Jowett J.B., Stewart S.A., Xie Y.M., Garfinkel A., Shibagaki Y., Chow S.A., Shah N., Hanaoka F., Sawitz D.G., Armstrong R.W., Souza L.M., Chen I.S.J. Virol. 71:9732-9742(1997) Two human homologs of Rad23 are functionally interchangeable in complex formation and stimulation of XPC repair activity.Sugasawa K., Ng J.M., Masutani C., Maekawa T., Uchida A., van der Spek P.J., Eker A.P., Rademakers S., Visser C., Aboussekhra A., Wood R.D., Hanaoka F., Bootsma D., Hoeijmakers J.H.Mol. Cell. Biol. 17:6924-6931(1997) Interaction of hHR23 with S5a. The ubiquitin-like domain of hHR23 mediates interaction with S5a subunit of 26 S proteasome.Hiyama H., Yokoi M., Masutani C., Sugasawa K., Maekawa T., Tanaka K., Hoeijmakers J.H., Hanaoka F.J. Biol. Chem. 274:28019-28025(1999) Ataxin-3, the MJD1 gene product, interacts with the two human homologs of yeast DNA repair protein RAD23, HHR23A and HHR23B.Wang G., Sawai N., Kotliarova S., Kanazawa I., Nukina N.Hum. Mol. Genet. 9:1795-1803(2000) Ubiquitin recognition by the DNA repair protein hHR23a.Wang Q., Goh A.M., Howley P.M., Walters K.J.Biochemistry 42:13529-13535(2003) Rad23 ubiquitin-associated domains (UBA) inhibit 26 S proteasome-catalyzed proteolysis by sequestering lysine 48-linked polyubiquitin chains.Raasi S., Pickart C.M.J. Biol. Chem. 278:8951-8959(2003) Binding of polyubiquitin chains to ubiquitin-associated (UBA) domains of HHR23A.Raasi S., Orlov I., Fleming K.G., Pickart C.M.J. Mol. Biol. 341:1367-1379(2004) Evidence for distinct functions for human DNA repair factors hHR23A and hHR23B.Chen L., Madura K.FEBS Lett. 580:3401-3408(2006) Ubiquitin receptor proteins hHR23a and hPLIC2 interact.Kang Y., Zhang N., Koepp D.M., Walters K.J.J. Mol. Biol. 365:1093-1101(2007) ATM and ATR substrate analysis reveals extensive protein networks responsive to DNA damage.Matsuoka S., Ballif B.A., Smogorzewska A., McDonald E.R. III, Hurov K.E., Luo J., Bakalarski C.E., Zhao Z., Solimini N., Lerenthal Y., Shiloh Y., Gygi S.P., Elledge S.J.Science 316:1160-1166(2007) Components of the ubiquitin-proteasome pathway compete for surfaces on Rad23 family proteins.Goh A.M., Walters K.J., Elsasser S., Verma R., Deshaies R.J., Finley D., Howley P.M.BMC Biochem. 9:4-4(2008) A quantitative atlas of mitotic phosphorylation.Dephoure N., Zhou C., Villen J., Beausoleil S.A., Bakalarski C.E., Elledge S.J., Gygi S.P.Proc. Natl. Acad. Sci. U.S.A. 105:10762-10767(2008) Quantitative phosphoproteomic analysis of T cell receptor signaling reveals system-wide modulation of protein-protein interactions.Mayya V., Lundgren D.H., Hwang S.-I., Rezaul K., Wu L., Eng J.K., Rodionov V., Han D.K.Sci. Signal. 2:RA46-RA46(2009) HIV-1 replication through hHR23A-mediated interaction of Vpr with 26S proteasome.Li G., Elder R.T., Dubrovsky L., Liang D., Pushkarsky T., Chiu K., Fan T., Sire J., Bukrinsky M., Zhao R.Y.PLoS ONE 5:E11371-E11371(2010) Quantitative phosphoproteomics reveals widespread full phosphorylation site occupancy during mitosis.Olsen J.V., Vermeulen M., Santamaria A., Kumar C., Miller M.L., Jensen L.J., Gnad F., Cox J., Jensen T.S., Nigg E.A., Brunak S., Mann M.Sci. Signal. 3:RA3-RA3(2010) Initial characterization of the human central proteome.Burkard T.R., Planyavsky M., Kaupe I., Breitwieser F.P., Buerckstuemmer T., Bennett K.L., Superti-Furga G., Colinge J.BMC Syst. Biol. 5:17-17(2011) System-wide temporal characterization of the proteome and phosphoproteome of human embryonic stem cell differentiation.Rigbolt K.T., Prokhorova T.A., Akimov V., Henningsen J., Johansen P.T., Kratchmarova I., Kassem M., Mann M., Olsen J.V., Blagoev B.Sci. Signal. 4:RS3-RS3(2011) An enzyme assisted RP-RPLC approach for in-depth analysis of human liver phosphoproteome.Bian Y., Song C., Cheng K., Dong M., Wang F., Huang J., Sun D., Wang L., Ye M., Zou H.J. Proteomics 96:253-262(2014) Structure of a human DNA repair protein UBA domain that interacts with HIV-1 Vpr.Dieckmann T., Withers-Ward E.S., Jarosinski M.A., Liu C.F., Chen I.S.Y., Feigon J.Nat. Struct. Biol. 5:1042-1047(1998) Biochemical and structural analysis of the interaction between the UBA(2) domain of the DNA repair protein HHR23A and HIV-1 Vpr.Withers-Ward E.S., Mueller T.D., Chen I.S.Y., Feigon J.Biochemistry 39:14103-14112(2000) Solution structures of UBA domains reveal a conserved hydrophobic surface for protein-protein interactions.Mueller T.D., Feigon J.J. Mol. Biol. 319:1243-1255(2002) Structural determinants for the binding of ubiquitin-like domains to the proteasome.Mueller T.D., Feigon J.EMBO J. 22:4634-4645(2003) DNA-repair protein hHR23a alters its protein structure upon binding proteasomal subunit S5a.Walters K.J., Lech P.J., Goh A.M., Wang Q., Howley P.M.Proc. Natl. Acad. Sci. U.S.A. 100:12694-12699(2003) Structure of the XPC binding domain of hHR23A reveals hydrophobic patches for protein interaction.Kamionka M., Feigon J.Protein Sci. 13:2370-2377(2004) Structural determinants for selective recognition of a Lys48-linked polyubiquitin chain by a UBA domain.Varadan R., Assfalg M., Raasi S., Pickart C., Fushman D.Mol. Cell 18:687-698(2005)
NCBI and Uniprot Product Information
NCBI GI #
NCBI GeneID
NCBI Accession #
NCBI GenBank Nucleotide #
Molecular Weight
41.6 kDa
NCBI Official Full Name
UV excision repair protein RAD23 homolog A isoform 2
NCBI Official Synonym Full Names
RAD23 homolog A, nucleotide excision repair protein
NCBI Official Symbol
RAD23A
NCBI Official Synonym Symbols
HR23A; HHR23A
NCBI Protein Information
UV excision repair protein RAD23 homolog A
UniProt Protein Name
UV excision repair protein RAD23 homolog A
UniProt Gene Name
RAD23A
UniProt Synonym Gene Names
HR23A; hHR23A
UniProt Entry Name
RD23A_HUMAN
Customer Reviews
Loading reviews...
Share Your Experience
Similar Products
Product Notes
The RAD23A rad23a (Catalog #AAA81657) is a Recombinant Protein produced from E Coli or Yeast or Baculovirus or Mammalian Cell and is intended for research purposes only. The product is available for immediate purchase. The immunogen sequence is 1-363aa; Full Length. The amino acid sequence is listed below: MAVTITLKTL QQQTFKIRME PDETVKVLKE KIEAEKGRDA FPVAGQKLIY AGKILSDDVP IRDYRIDEKN FVVVMVTKTK AGQGTSAPPE ASPTAAPESS TSFPPAPTSG MSHPPPAARE DKSPSEESAP TTSPESVSGS VPSSGSSGRE EDAASTLVTG SEYETMLTEI MSMGYERERV VAALRASYNN PHRAVEYLLT GIPGSPEPEH GSVQESQVSE QPATEAAGEN PLEFLRDQPQ FQNMRQVIQQ NPALLPALLQ QLGQENPQLL QQISRHQEQF IQMLNEPPGE LADISDVEGE VGAIGEEAPQ MNYIQVTPQE KEAIERLKAL GFPESLVIQA YFACEKNENL AANFLLSQNF DDE. It is sometimes possible for the material contained within the vial of "UV excision repair protein RAD23 homolog A, Recombinant Protein" to become dispersed throughout the inside of the vial, particularly around the seal of said vial, during shipment and storage. We always suggest centrifuging these vials to consolidate all of the liquid away from the lid and to the bottom of the vial prior to opening. Please be advised that certain products may require dry ice for shipping and that, if this is the case, an additional dry ice fee may also be required.Precautions
All products in the AAA Biotech catalog are strictly for research-use only, and are absolutely not suitable for use in any sort of medical, therapeutic, prophylactic, in-vivo, or diagnostic capacity. By purchasing a product from AAA Biotech, you are explicitly certifying that said products will be properly tested and used in line with industry standard. AAA Biotech and its authorized distribution partners reserve the right to refuse to fulfill any order if we have any indication that a purchaser may be intending to use a product outside of our accepted criteria.Disclaimer
Though we do strive to guarantee the information represented in this datasheet, AAA Biotech cannot be held responsible for any oversights or imprecisions. AAA Biotech reserves the right to adjust any aspect of this datasheet at any time and without notice. It is the responsibility of the customer to inform AAA Biotech of any product performance issues observed or experienced within 30 days of receipt of said product. To see additional details on this or any of our other policies, please see our Terms & Conditions page.Item has been added to Shopping Cart
If you are ready to order, navigate to Shopping Cart and get ready to checkout.